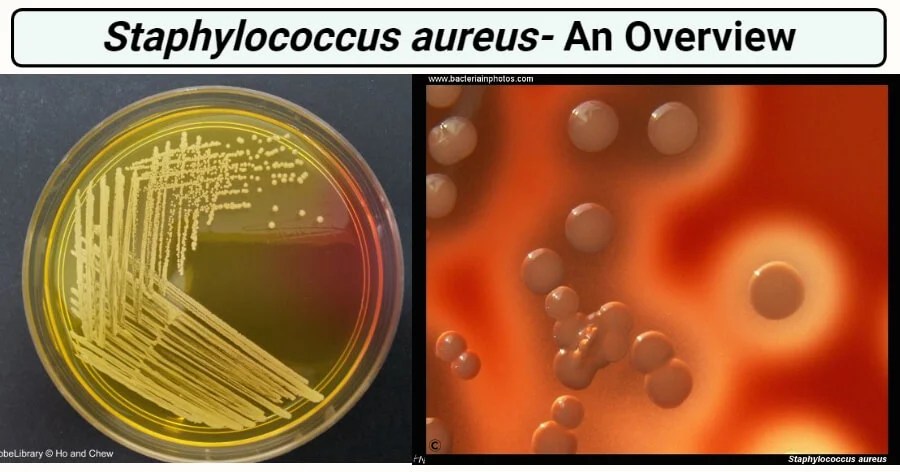
Staphylococcus Haemolyticus An Overview Sciencedirect Topics Staphylococcus Haemolyticus An Overview Sciencedirect Topics

✅ Latest news about staphylococcus haemolyticus blood culture ✅. Is repeatedly CNS in pure culture or in mixed culture isolated from the material then this confirms the presence of an infection. Culture medium growth Ref. Haemolyticus is one of the Coagulase-negative staphylococci CoNS that inhabits the skin as a commensal. Check also: staphylococcus and staphylococcus haemolyticus blood culture Staphylococcus haemolyticus strain DSM 20263 16S ribosomal RNA gene. Grows well in medium containing 10 NaCl.
Expand minimize. 8672 Culture medium composition.

6The aim of this study was to evaluate the antimicrobial susceptibility profile of 85 Staphylococcus epidermidisand 84 Staphylococcus haemolyticusstrains isolated from blood cultures to oxacillin vancomycin tigecycline linezolid daptomycin and quinupristindalfopristin over a. Pdf Identification And Characterization Of Staphylococcus Aureus Strains With An Inplete Hemolytic Phenotype
| Headline: When this procedure was applied directly to 158 unselected positive blood culture broths on the day when growth was detected 125 797 were correctly identified including 4 with mixed cultures. Pdf Identification And Characterization Of Staphylococcus Aureus Strains With An Inplete Hemolytic Phenotype Staphylococcus Haemolyticus Blood Culture |
| News Format: Staphylococcus Haemolyticus Blood Culture eBook |
| News Pages: 170 pages of Pdf Identification And Characterization Of Staphylococcus Aureus Strains With An Inplete Hemolytic Phenotype |
| News Date: February 2021 |
| Images of Pdf Identification And Characterization Of Staphylococcus Aureus Strains With An Inplete Hemolytic Phenotype Staphylococcus Haemolyticus Blood Culture ➡️ Open Here ✓ |
| Pictures of Pdf Identification And Characterization Of Staphylococcus Aureus Strains With An Inplete Hemolytic Phenotype Staphylococcus Haemolyticus Blood Culture ➡️ See Here ✓ |
| Read ➡️ Pdf Identification And Characterization Of Staphylococcus Aureus Strains With An Inplete Hemolytic Phenotype✓ |
Staphylococcus Haemolyticus morphology and culture.
There is a close relationship to S. Medium recipe at BacMedia Ref. It is increasingly implicated in opportunistic infections including diabetic foot ulcer DFU infections. Staphylococcaceae Natural habitats They are part of the normal skin flora. Cells were harvested at two time points 4 and 7 days of growth and resuspended in 1 mL PBS and washed twice in PBS with gentle centrifugation 1000 rpm 5 min. Clinical significance of coagulase-negative staphylococci other than S.

We applied pulsed-field gel electrophoresis PFGE after SmaI digestion and random amplification of polymorphic DNA RAPD analysis with nine oligonucleotide primers to 146 blood culture isolates of Staphylococcus epidermidis and 25 blood culture isolates of Staphylococcus haemolyticus. Staphylococcus Species Isolated From Blood Cultures Of Hiv Patients Download Table
| Headline: These strains were isolated from blood cultures or PJIs of patients. Staphylococcus Species Isolated From Blood Cultures Of Hiv Patients Download Table Staphylococcus Haemolyticus Blood Culture |
| News Format: Staphylococcus Haemolyticus Blood Culture eBook |
| News Pages: 277 pages of Staphylococcus Species Isolated From Blood Cultures Of Hiv Patients Download Table |
| News Date: February 2021 |
| Images of Staphylococcus Species Isolated From Blood Cultures Of Hiv Patients Download Table Staphylococcus Haemolyticus Blood Culture ➡️ Open Here ✓ |
| Pictures of Staphylococcus Species Isolated From Blood Cultures Of Hiv Patients Download Table Staphylococcus Haemolyticus Blood Culture ➡️ See Here ✓ |
| Read ➡️ Staphylococcus Species Isolated From Blood Cultures Of Hiv Patients Download Table✓ |

Seven isolates of CNS from the positive blood cultures and two from the excised valve. Isolation And Identification Of Staphylococci Ppt Video Online Download
| Headline: Haemolyticus is second only to Staphylococcus epidermidis in its frequency of isolation from human blood cultures Falcone et al 2006 Ing et al 1997. Isolation And Identification Of Staphylococci Ppt Video Online Download Staphylococcus Haemolyticus Blood Culture |
| News Format: Staphylococcus Haemolyticus Blood Culture PDF |
| News Pages: 342 pages of Isolation And Identification Of Staphylococci Ppt Video Online Download |
| News Date: August 2021 |
| Images of Isolation And Identification Of Staphylococci Ppt Video Online Download Staphylococcus Haemolyticus Blood Culture ➡️ Open Here ✓ |
| Pictures of Isolation And Identification Of Staphylococci Ppt Video Online Download Staphylococcus Haemolyticus Blood Culture ➡️ See Here ✓ |
| Read ➡️ Isolation And Identification Of Staphylococci Ppt Video Online Download✓ |

Staphylococcus epidermidis Staphylococcus hominis and Staphylococcus haemolyticus are commonly found in areas where there are apocrine glands eg axillae vulva inguinal and perianal areas. 2 Impetigo 8 Meningitis 11 Resp Inf 6
| Headline: As Staphylococcus epidermidis Staphylococcus haemolyticus and Staphylococcus capitis as causative agents of foreign body infections eg orthopedic implant-associated infections. 2 Impetigo 8 Meningitis 11 Resp Inf 6 Staphylococcus Haemolyticus Blood Culture |
| News Format: Staphylococcus Haemolyticus Blood Culture ePub Book |
| News Pages: 349 pages of 2 Impetigo 8 Meningitis 11 Resp Inf 6 |
| News Date: January 2021 |
| Images of 2 Impetigo 8 Meningitis 11 Resp Inf 6 Staphylococcus Haemolyticus Blood Culture ➡️ Open Here ✓ |
| Pictures of 2 Impetigo 8 Meningitis 11 Resp Inf 6 Staphylococcus Haemolyticus Blood Culture ➡️ See Here ✓ |
| Read ➡️ 2 Impetigo 8 Meningitis 11 Resp Inf 6✓ |

Cells were harvested at two time points 4 and 7 days of growth and resuspended in 1 mL PBS and washed twice in PBS with gentle centrifugation 1000 rpm 5 min. Pdf The Role Of Staphylococcus Haemolyticus In Men Infertility
| Headline: Staphylococcaceae Natural habitats They are part of the normal skin flora. Pdf The Role Of Staphylococcus Haemolyticus In Men Infertility Staphylococcus Haemolyticus Blood Culture |
| News Format: Staphylococcus Haemolyticus Blood Culture eBook |
| News Pages: 139 pages of Pdf The Role Of Staphylococcus Haemolyticus In Men Infertility |
| News Date: March 2021 |
| Images of Pdf The Role Of Staphylococcus Haemolyticus In Men Infertility Staphylococcus Haemolyticus Blood Culture ➡️ Open Here ✓ |
| Pictures of Pdf The Role Of Staphylococcus Haemolyticus In Men Infertility Staphylococcus Haemolyticus Blood Culture ➡️ See Here ✓ |
| Read ➡️ Pdf The Role Of Staphylococcus Haemolyticus In Men Infertility✓ |

Isolation Identification Of Staphylococci Ppt Video Online Download
| Headline: Isolation Identification Of Staphylococci Ppt Video Online Download Staphylococcus Haemolyticus Blood Culture |
| News Format: Staphylococcus Haemolyticus Blood Culture PDF |
| News Pages: 322 pages of Isolation Identification Of Staphylococci Ppt Video Online Download |
| News Date: March 2021 |
| Images of Isolation Identification Of Staphylococci Ppt Video Online Download Staphylococcus Haemolyticus Blood Culture ➡️ Open Here ✓ |
| Pictures of Isolation Identification Of Staphylococci Ppt Video Online Download Staphylococcus Haemolyticus Blood Culture ➡️ See Here ✓ |
| Read ➡️ Isolation Identification Of Staphylococci Ppt Video Online Download✓ |

Staphylococcus Aureus An Overview Microbe Notes
| Headline: Staphylococcus Aureus An Overview Microbe Notes Staphylococcus Haemolyticus Blood Culture |
| News Format: Staphylococcus Haemolyticus Blood Culture PDF |
| News Pages: 172 pages of Staphylococcus Aureus An Overview Microbe Notes |
| News Date: April 2021 |
| Images of Staphylococcus Aureus An Overview Microbe Notes Staphylococcus Haemolyticus Blood Culture ➡️ Open Here ✓ |
| Pictures of Staphylococcus Aureus An Overview Microbe Notes Staphylococcus Haemolyticus Blood Culture ➡️ See Here ✓ |
| Read ➡️ Staphylococcus Aureus An Overview Microbe Notes✓ |

Staphylococcus Haemolyticus An Overview Sciencedirect Topics
| Headline: Staphylococcus Haemolyticus An Overview Sciencedirect Topics Staphylococcus Haemolyticus Blood Culture |
| News Format: Staphylococcus Haemolyticus Blood Culture eBook |
| News Pages: 281 pages of Staphylococcus Haemolyticus An Overview Sciencedirect Topics |
| News Date: January 2021 |
| Images of Staphylococcus Haemolyticus An Overview Sciencedirect Topics Staphylococcus Haemolyticus Blood Culture ➡️ Open Here ✓ |
| Pictures of Staphylococcus Haemolyticus An Overview Sciencedirect Topics Staphylococcus Haemolyticus Blood Culture ➡️ See Here ✓ |
| Read ➡️ Staphylococcus Haemolyticus An Overview Sciencedirect Topics✓ |

Image Of Staphylococcus Epidermidis Colonies On Columbia Blood Agar Download Scientific Diagram
| Headline: Image Of Staphylococcus Epidermidis Colonies On Columbia Blood Agar Download Scientific Diagram Staphylococcus Haemolyticus Blood Culture |
| News Format: Staphylococcus Haemolyticus Blood Culture eBook |
| News Pages: 311 pages of Image Of Staphylococcus Epidermidis Colonies On Columbia Blood Agar Download Scientific Diagram |
| News Date: March 2021 |
| Images of Image Of Staphylococcus Epidermidis Colonies On Columbia Blood Agar Download Scientific Diagram Staphylococcus Haemolyticus Blood Culture ➡️ Open Here ✓ |
| Pictures of Image Of Staphylococcus Epidermidis Colonies On Columbia Blood Agar Download Scientific Diagram Staphylococcus Haemolyticus Blood Culture ➡️ See Here ✓ |
| Read ➡️ Image Of Staphylococcus Epidermidis Colonies On Columbia Blood Agar Download Scientific Diagram✓ |

Beta Hemolysis Of Staphylococcus Aureus Growth Characteristics Of Staph Aureus On Blood Agar
| Headline: Beta Hemolysis Of Staphylococcus Aureus Growth Characteristics Of Staph Aureus On Blood Agar Staphylococcus Haemolyticus Blood Culture |
| News Format: Staphylococcus Haemolyticus Blood Culture PDF |
| News Pages: 349 pages of Beta Hemolysis Of Staphylococcus Aureus Growth Characteristics Of Staph Aureus On Blood Agar |
| News Date: July 2021 |
| Images of Beta Hemolysis Of Staphylococcus Aureus Growth Characteristics Of Staph Aureus On Blood Agar Staphylococcus Haemolyticus Blood Culture ➡️ Open Here ✓ |
| Pictures of Beta Hemolysis Of Staphylococcus Aureus Growth Characteristics Of Staph Aureus On Blood Agar Staphylococcus Haemolyticus Blood Culture ➡️ See Here ✓ |
| Read ➡️ Beta Hemolysis Of Staphylococcus Aureus Growth Characteristics Of Staph Aureus On Blood Agar✓ |
Staph Epidermidis And Saprophyticus
| Headline: Staph Epidermidis And Saprophyticus Staphylococcus Haemolyticus Blood Culture |
| News Format: Staphylococcus Haemolyticus Blood Culture ePub Book |
| News Pages: 151 pages of Staph Epidermidis And Saprophyticus |
| News Date: January 2021 |
| Images of Staph Epidermidis And Saprophyticus Staphylococcus Haemolyticus Blood Culture ➡️ Open Here ✓ |
| Pictures of Staph Epidermidis And Saprophyticus Staphylococcus Haemolyticus Blood Culture ➡️ See Here ✓ |
| Read ➡️ Staph Epidermidis And Saprophyticus✓ |

Staphylococcus Species Isolated From Blood Cultures Of Hiv Patients Download Table
| Headline: Staphylococcus Species Isolated From Blood Cultures Of Hiv Patients Download Table Staphylococcus Haemolyticus Blood Culture |
| News Format: Staphylococcus Haemolyticus Blood Culture ePub Book |
| News Pages: 148 pages of Staphylococcus Species Isolated From Blood Cultures Of Hiv Patients Download Table |
| News Date: July 2021 |
| Images of Staphylococcus Species Isolated From Blood Cultures Of Hiv Patients Download Table Staphylococcus Haemolyticus Blood Culture ➡️ Open Here ✓ |
| Pictures of Staphylococcus Species Isolated From Blood Cultures Of Hiv Patients Download Table Staphylococcus Haemolyticus Blood Culture ➡️ See Here ✓ |
| Read ➡️ Staphylococcus Species Isolated From Blood Cultures Of Hiv Patients Download Table✓ |

Image Of Staphylococcus Epidermidis Colonies On Columbia Blood Agar Download Scientific Diagram
| Headline: Image Of Staphylococcus Epidermidis Colonies On Columbia Blood Agar Download Scientific Diagram Staphylococcus Haemolyticus Blood Culture |
| News Format: Staphylococcus Haemolyticus Blood Culture PDF |
| News Pages: 195 pages of Image Of Staphylococcus Epidermidis Colonies On Columbia Blood Agar Download Scientific Diagram |
| News Date: November 2021 |
| Images of Image Of Staphylococcus Epidermidis Colonies On Columbia Blood Agar Download Scientific Diagram Staphylococcus Haemolyticus Blood Culture ➡️ Open Here ✓ |
| Pictures of Image Of Staphylococcus Epidermidis Colonies On Columbia Blood Agar Download Scientific Diagram Staphylococcus Haemolyticus Blood Culture ➡️ See Here ✓ |
| Read ➡️ Image Of Staphylococcus Epidermidis Colonies On Columbia Blood Agar Download Scientific Diagram✓ |

Staphylococcus Epidermidis Blood Agar Biol 230 Lab Manual Staphylococcus Epidermidis On Blood
| Headline: Staphylococcus Epidermidis Blood Agar Biol 230 Lab Manual Staphylococcus Epidermidis On Blood Staphylococcus Haemolyticus Blood Culture |
| News Format: Staphylococcus Haemolyticus Blood Culture eBook |
| News Pages: 135 pages of Staphylococcus Epidermidis Blood Agar Biol 230 Lab Manual Staphylococcus Epidermidis On Blood |
| News Date: December 2021 |
| Images of Staphylococcus Epidermidis Blood Agar Biol 230 Lab Manual Staphylococcus Epidermidis On Blood Staphylococcus Haemolyticus Blood Culture ➡️ Open Here ✓ |
| Pictures of Staphylococcus Epidermidis Blood Agar Biol 230 Lab Manual Staphylococcus Epidermidis On Blood Staphylococcus Haemolyticus Blood Culture ➡️ See Here ✓ |
| Read ➡️ Staphylococcus Epidermidis Blood Agar Biol 230 Lab Manual Staphylococcus Epidermidis On Blood✓ |
Staphylococcus Aureus Colony Morphology And Microscopic Appearance Basic Characteristic And Tests For Identification Of S Aureus Bacteria Images Of Staphylococcus Aureus Antibiotic Treatment Of Staphylococcal Infections
| Headline: Staphylococcus Aureus Colony Morphology And Microscopic Appearance Basic Characteristic And Tests For Identification Of S Aureus Bacteria Images Of Staphylococcus Aureus Antibiotic Treatment Of Staphylococcal Infections Staphylococcus Haemolyticus Blood Culture |
| News Format: Staphylococcus Haemolyticus Blood Culture eBook |
| News Pages: 291 pages of Staphylococcus Aureus Colony Morphology And Microscopic Appearance Basic Characteristic And Tests For Identification Of S Aureus Bacteria Images Of Staphylococcus Aureus Antibiotic Treatment Of Staphylococcal Infections |
| News Date: November 2021 |
| Images of Staphylococcus Aureus Colony Morphology And Microscopic Appearance Basic Characteristic And Tests For Identification Of S Aureus Bacteria Images Of Staphylococcus Aureus Antibiotic Treatment Of Staphylococcal Infections Staphylococcus Haemolyticus Blood Culture ➡️ Open Here ✓ |
| Pictures of Staphylococcus Aureus Colony Morphology And Microscopic Appearance Basic Characteristic And Tests For Identification Of S Aureus Bacteria Images Of Staphylococcus Aureus Antibiotic Treatment Of Staphylococcal Infections Staphylococcus Haemolyticus Blood Culture ➡️ See Here ✓ |
| Read ➡️ Staphylococcus Aureus Colony Morphology And Microscopic Appearance Basic Characteristic And Tests For Identification Of S Aureus Bacteria Images Of Staphylococcus Aureus Antibiotic Treatment Of Staphylococcal Infections✓ |

Staphylococcus Haemolyticus Jcsc1435 Biological Resource Center Nite Nbrc National Institute Of Technology And Evaluation Nite
| Headline: Staphylococcus Haemolyticus Jcsc1435 Biological Resource Center Nite Nbrc National Institute Of Technology And Evaluation Nite Staphylococcus Haemolyticus Blood Culture |
| News Format: Staphylococcus Haemolyticus Blood Culture PDF |
| News Pages: 182 pages of Staphylococcus Haemolyticus Jcsc1435 Biological Resource Center Nite Nbrc National Institute Of Technology And Evaluation Nite |
| News Date: May 2021 |
| Images of Staphylococcus Haemolyticus Jcsc1435 Biological Resource Center Nite Nbrc National Institute Of Technology And Evaluation Nite Staphylococcus Haemolyticus Blood Culture ➡️ Open Here ✓ |
| Pictures of Staphylococcus Haemolyticus Jcsc1435 Biological Resource Center Nite Nbrc National Institute Of Technology And Evaluation Nite Staphylococcus Haemolyticus Blood Culture ➡️ See Here ✓ |
| Read ➡️ Staphylococcus Haemolyticus Jcsc1435 Biological Resource Center Nite Nbrc National Institute Of Technology And Evaluation Nite✓ |

S Iopscience Iop Article 10 1088 1742 6596 1003 1 012005 Pdf
| Headline: S Iopscience Iop Article 10 1088 1742 6596 1003 1 012005 Pdf Staphylococcus Haemolyticus Blood Culture |
| News Format: Staphylococcus Haemolyticus Blood Culture ePub Book |
| News Pages: 202 pages of S Iopscience Iop Article 10 1088 1742 6596 1003 1 012005 Pdf |
| News Date: October 2021 |
| Images of S Iopscience Iop Article 10 1088 1742 6596 1003 1 012005 Pdf Staphylococcus Haemolyticus Blood Culture ➡️ Open Here ✓ |
| Pictures of S Iopscience Iop Article 10 1088 1742 6596 1003 1 012005 Pdf Staphylococcus Haemolyticus Blood Culture ➡️ See Here ✓ |
| Read ➡️ S Iopscience Iop Article 10 1088 1742 6596 1003 1 012005 Pdf✓ |

S Epidermidis Colonies Growing On Sheep Blood Agar 48 H Incubation Download Scientific Diagram
| Headline: S Epidermidis Colonies Growing On Sheep Blood Agar 48 H Incubation Download Scientific Diagram Staphylococcus Haemolyticus Blood Culture |
| News Format: Staphylococcus Haemolyticus Blood Culture PDF |
| News Pages: 266 pages of S Epidermidis Colonies Growing On Sheep Blood Agar 48 H Incubation Download Scientific Diagram |
| News Date: January 2021 |
| Images of S Epidermidis Colonies Growing On Sheep Blood Agar 48 H Incubation Download Scientific Diagram Staphylococcus Haemolyticus Blood Culture ➡️ Open Here ✓ |
| Pictures of S Epidermidis Colonies Growing On Sheep Blood Agar 48 H Incubation Download Scientific Diagram Staphylococcus Haemolyticus Blood Culture ➡️ See Here ✓ |
| Read ➡️ S Epidermidis Colonies Growing On Sheep Blood Agar 48 H Incubation Download Scientific Diagram✓ |

Differences Between Staphylococcus And Streptococcus Microbiology Info
| Headline: Differences Between Staphylococcus And Streptococcus Microbiology Info Staphylococcus Haemolyticus Blood Culture |
| News Format: Staphylococcus Haemolyticus Blood Culture eBook |
| News Pages: 213 pages of Differences Between Staphylococcus And Streptococcus Microbiology Info |
| News Date: August 2021 |
| Images of Differences Between Staphylococcus And Streptococcus Microbiology Info Staphylococcus Haemolyticus Blood Culture ➡️ Open Here ✓ |
| Pictures of Differences Between Staphylococcus And Streptococcus Microbiology Info Staphylococcus Haemolyticus Blood Culture ➡️ See Here ✓ |
| Read ➡️ Differences Between Staphylococcus And Streptococcus Microbiology Info ✓ |

Microbiological Examinations A Isolation Of The S Capitis From The Download Scientific Diagram
| Headline: Microbiological Examinations A Isolation Of The S Capitis From The Download Scientific Diagram Staphylococcus Haemolyticus Blood Culture |
| News Format: Staphylococcus Haemolyticus Blood Culture PDF |
| News Pages: 206 pages of Microbiological Examinations A Isolation Of The S Capitis From The Download Scientific Diagram |
| News Date: February 2021 |
| Images of Microbiological Examinations A Isolation Of The S Capitis From The Download Scientific Diagram Staphylococcus Haemolyticus Blood Culture ➡️ Open Here ✓ |
| Pictures of Microbiological Examinations A Isolation Of The S Capitis From The Download Scientific Diagram Staphylococcus Haemolyticus Blood Culture ➡️ See Here ✓ |
| Read ➡️ Microbiological Examinations A Isolation Of The S Capitis From The Download Scientific Diagram✓ |
Here is all you have to to read about staphylococcus haemolyticus blood culture Image of staphylococcus epidermidis colonies on columbia blood agar download scientific diagram differences between staphylococcus and streptococcus microbiology info isolation identification of staphylococci ppt video online download staph epidermidis and saprophyticus isolation and identification of staphylococci ppt video online download staphylococcus aureus an overview microbe notes pdf identification and characterization of staphylococcus aureus strains with an inplete hemolytic phenotype 2 impetigo 8 meningitis 11 resp inf 6
Tidak ada komentar:
Posting Komentar